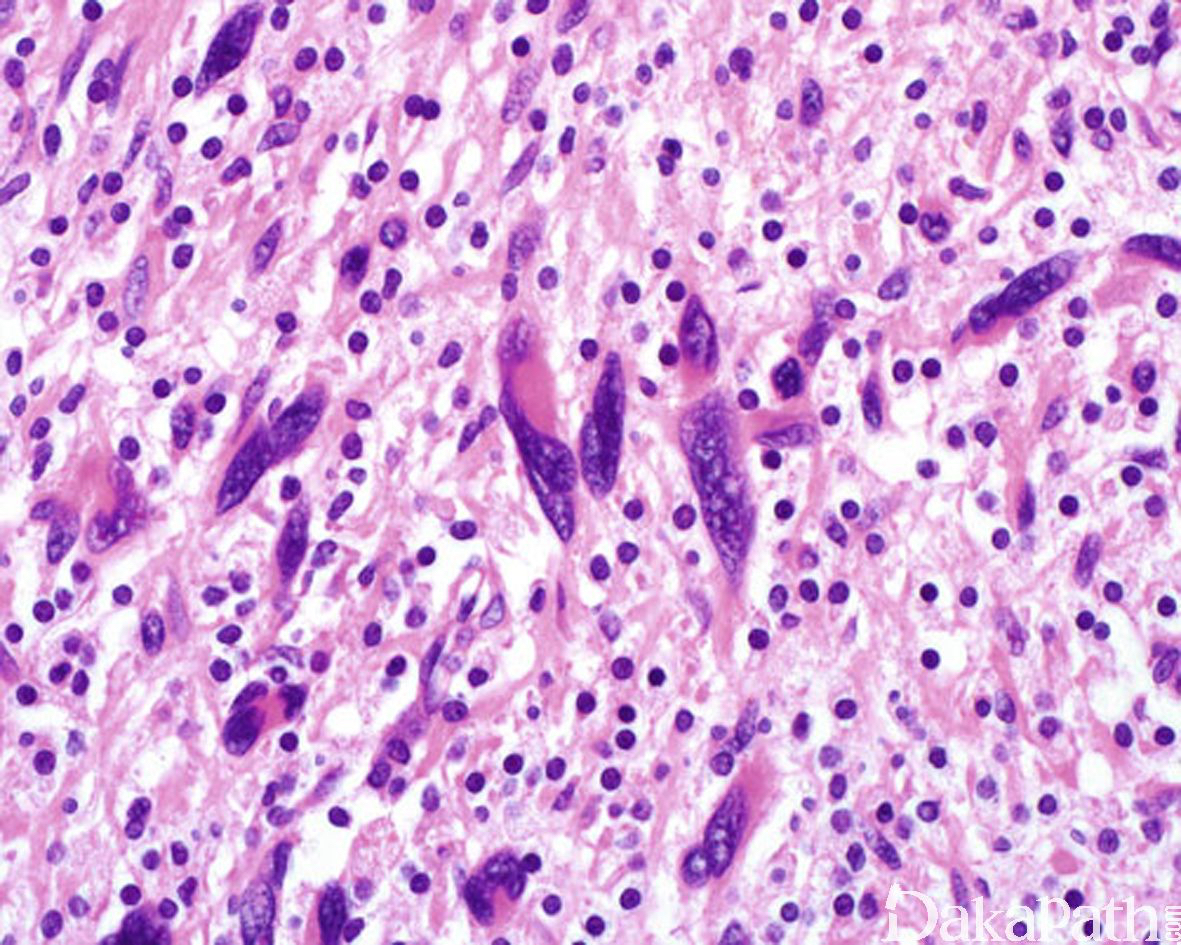

非典型神经纤维瘤
Atypical Neurofibroma
同义词(或曾用名): 细胞性神经纤维瘤、伴有非典型性的神经纤维瘤
概述:
神经纤维瘤是良性周围神经鞘膜肿瘤,由施万细胞、纤维细胞母及少量的轴突、神经束膜细胞共同构成。
发病部位: 任何年龄均可受累,但最常见于年轻成人; 通常发生于全身的皮肤或皮下组织;大体表现为界清楚的纺锤形病变,常与神经干有关;切面质硬、灰白色;
诊断要点:
在神经纤维瘤形态学结构基础上,出现散在、核大、染色质呈污浊状,核仁不明显,核内可见胞质性的包涵体的核异型细胞,无核分裂像。

免疫组织化学染色:
S-100. MBP、XIIIa、CD34 阳性,可见 EMA 阳性神经束膜细胞,NF 阳性的轴突成分;P53 阴性,Ki67 增殖指数低,H3K27me3 无表达丢失;多数病例无表达缺失,少数可出现表达缺失。
分子标记:
通常与 NF1 无关
鉴别诊断:
诊断术语 | 诊断标准和定义 |
神经纤维瘤 | 施万细胞伴有黏液和或胶原性间质以及纤维母细胞 |
非典型神经纤维瘤 | 神经纤维瘤仅有细胞非典型性 |
细胞性神经纤维瘤 | 神经纤维瘤伴瘤细胞密度增高,无束状/鱼骨样结构,核分裂象<1个/50HPF |
生物学潜能未定的非典型神经纤维瘤样肿瘤(ANNUBP) | 施万细胞肿瘤伴有2个或2个以上下列组织学特征:1,伴有细胞非典型性;2,富于细胞;3,束状和/或鱼骨样排列;4,1个/50HPF<核分裂象<3个/10HPF |
低级别恶性外周神经鞘膜瘤 | ANNUBP伴有核分裂象3-9个/10HPF,无肿瘤性坏死 |
高级别恶性外周神经鞘膜瘤 | MPNST伴有核分裂象≥10/10HPF和肿瘤性坏死 |
预后:
局部切除多可治愈,极少数神经纤维瘤(特别是与 NF1 相关者)可发生恶变。建议临床注意随访。
治疗:
局部切除
参考文献:
王坚,朱雄增. 《软组织肿瘤病理学》(第二版). 北京:人民卫生出版社, 2017 年。
